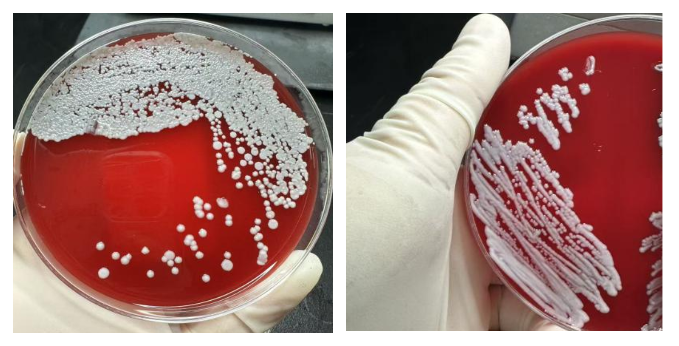

在医院这个庞大而精密的系统中,临床检验中心微生物室扮演着“病原侦探”的角色。他们不直接治疗病人,却为前线的临床医生提供着至关重要的“敌情”情报。近日,我院临床检验中心微生物室就成功识别并处置了一例“超级真菌”——耳念珠菌的检出案例,彰显了精准诊断和快速响应在感染控制中的核心价值。 病例分析 患者是一位因车祸导致的后背伤口感染严重的危重病人,技术人员按常规接收标本,1天后血平板上可见极微小的细菌生长,涂片镜检为酵母样真菌孢子,工作人员将该菌接种至2个沙保培养基上,分别放至30
在医院这个庞大而精密的系统中,临床检验中心微生物室扮演着“病原侦探”的角色。他们不直接治疗病人,却为前线的临床医生提供着至关重要的“敌情”情报。近日,我院临床检验中心微生物室就成功识别并处置了一例“超级真菌”——耳念珠菌的检出案例,彰显了精准诊断和快速响应在感染控制中的核心价值。
病例分析
患者是一位因车祸导致的后背伤口感染严重的危重病人,技术人员按常规接收标本,1天后血平板上可见极微小的细菌生长,涂片镜检为酵母样真菌孢子,工作人员将该菌接种至2个沙保培养基上,分别放至30度和35度孵育箱中,进行培养,1天后沙保培养基上长出白色,光滑的菌落,随后技术人员通过全自动细菌鉴定仪进行菌种鉴定同时将培养出的细菌送至专门机构进行质谱鉴定复核,确定为耳念珠菌,此菌具有高耐药性,高致死率,和强大的传播能力,故微生物工作人员请示科室主任后第一时间上报医院公共卫生管理部,并通知主治医生,进行相关预防治疗,公共卫生管理部在接到报告后,迅速行动,及时介入,预防耳念珠菌造成院内感染。
菌落培养结果
科普时间——认识“超级真菌”耳念珠菌
1.什么是耳念珠菌?
耳念珠菌是一种新近发现的、具有严重威胁的酵母菌。它于2009年首次在日本一位患者的耳道分泌物中发现(因此得名“耳念珠菌”),但随后在全球多地引起医院内感染暴发。它被世界卫生组织(WHO)列为“紧急威胁”级别的真菌病原体。

2. 为什么它很危险?
多重耐药性强:这是它最可怕的特点。许多耳念珠菌菌株对临床常用的三大类抗真菌药物(唑类、多烯类、棘白菌素类)中的一类或多类耐药,甚至出现对三类药物均耐药的“泛耐药”菌株。这导致治疗选择极其有限,患者死亡率很高。
医院内传播能力强:与其他念珠菌不同,耳念珠菌非常容易在患者之间,以及通过被污染的环境表面(如床栏、医疗器械、桌椅等)和医护人员的手进行传播。它能以生物膜形式在各种物体表面长期存活,难以彻底清除。
3. 哪些人群是易感人群?
健康人通常不易感染耳念珠菌。它的主要攻击目标是免疫系统受损的危重病人,例如:
长期住院,尤其是住在ICU的患者,接受过广谱抗生素或抗真菌药物治疗的患者,有严重基础疾病(如糖尿病、癌症、慢性肾病)的患者,体内有留置导管(如中心静脉导管、导尿管)或接受过大型手术的患者。

4. 我们应如何应对?
对于医疗机构:加强微生物实验室的检测能力是关键。一旦发现,必须立即、强制性地报告给感染控制部门,并严格执行接触隔离、环境清洁和手卫生。
对于公众:不必过度恐慌,但需提高意识。探视住院亲友时,务必遵守医院的洗手和防护规定。若家中有成员被确诊感染或定植耳念珠菌,应严格遵循医护人员指导进行居家护理和环境清洁。

本次耳念珠菌的成功发现与处置,是我院多学科协作、共同捍卫医疗安全的一个缩影。它再次提醒我们,在人类与微生物的漫长博弈中,微生物实验室是前沿的“哨所”,精准的诊断是胜利的基石,而迅速、透明的信息传递和果断的干预,则是构筑起抵御“超级病原体”侵袭的最坚固防线。









 相关新闻
相关新闻